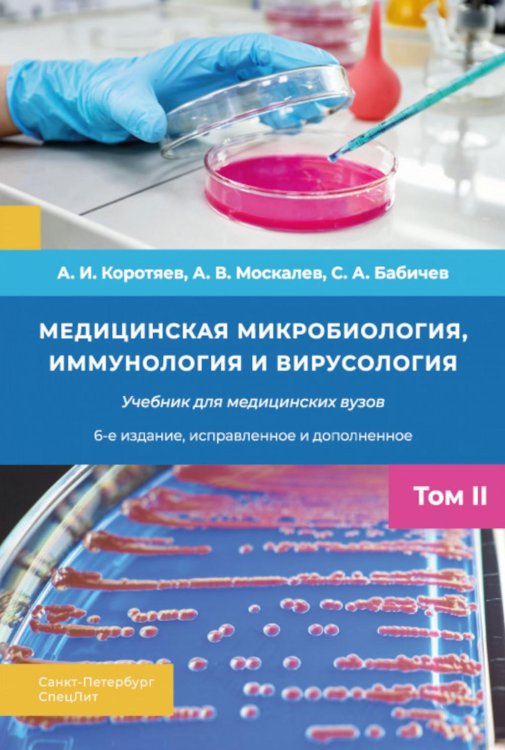
Медицинская микробиология, иммунология и вирусология: Учебник. В 2 т. Т. 2. 6-е изд., испр. и доп

Аннотация: Медицинская микробиология, иммунология и вирусология: Учебник. В 2 т. Т. 2. 6-е изд., испр. и доп
Учебник включает в себя курс общей микробиологии, иммунологии, вирусологии,бактериологии, микологии и санитарной микробиологии.В разделах вирусологии, бактериологии, микологии представлены сведения об основных биологических свойствах биологических агентов и о заболеваниях, которые они вызывают.Дополнительно к предыдущим изданиям введены новые части: «Санитарная микробиология» и «Патогенные грибы». Гораздо шире и на современном уровне представлены сведения о клеточных и гуморальных факторах врожденного и адаптивного иммунитета.В приложениях представлены основные требования противоэпидемического режима при работе в бактериологической лаборатории, виды микроскопирования и основные биологические методы исследования. Учебник предназначен для студентов, аспирантов и преподавателей высших медицинских учебных заведений, микробиологов всех специальностей и практических врачей.| Издательство | СпецЛит |
| Автор/составитель | Бабичев Сергей Анатольевич;Коротяев Александр Иванович;Москалев Александр Витальевич |
| Год выпуска | 2025 |
| Кол-во страниц | 677 |
| ISBN | 978-5-299-01211-8 |
| Кол-во томов | В 2 т. Т. 2 |
| Обложка | переплет-твердая обложка |
| Вес | 1067г |
| Формат | 17 x 25 cm |
| Тираж | 1000 |
| Возрастная категория | 16+ |
Бесплатная Доставка по Европе (EU)*
*Для заказов свыше 40, - евро Подробнее
Медицинская микробиология, иммунология и вирусология: Учебник. В 2 т. Т. 2. 6-е изд., испр. и доп
-17%- Производитель: СпецЛит
- Модель: TEEI11957210
- ISBN: 978-5-299-01211-8
- Наличие: Есть в наличии
-
Срок доставки: 21 день
- (14 оценок)
-
52.73€ 43.77€
Нашли этот товар по более низкой цене?
Во-первых - Вы молодец!
Во-первых - Вы молодец!
Просим Вас сообщить нам:


 Google
Google